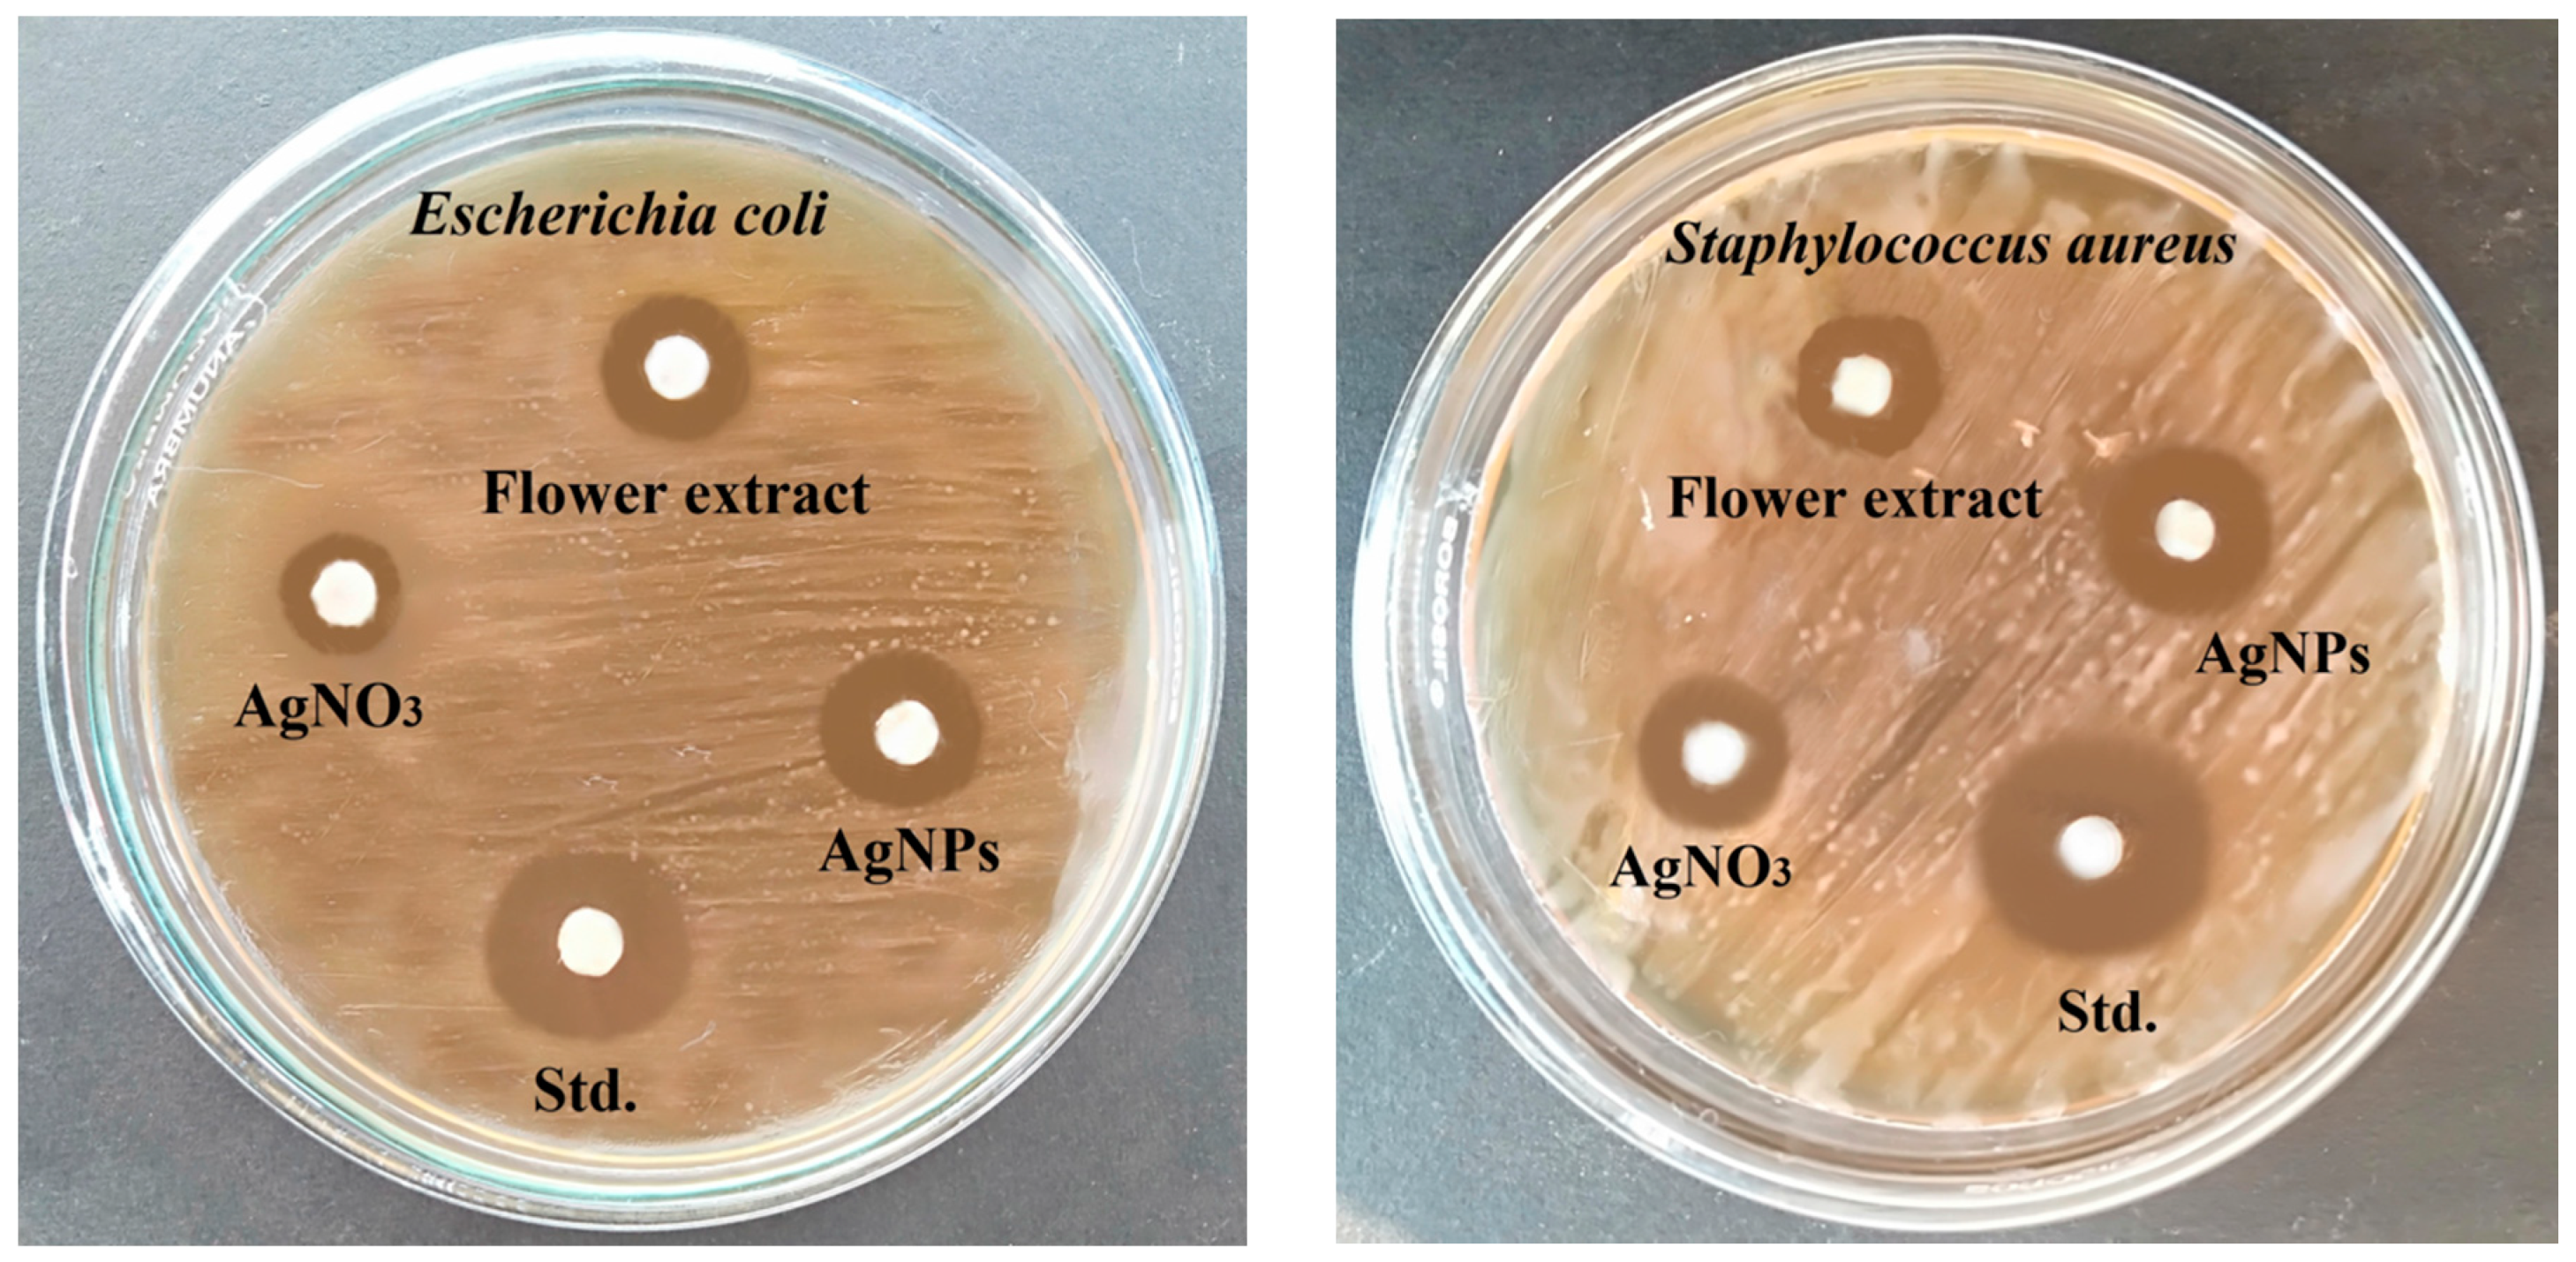
Antioxidants 10 01959 g006 550

Antibacterial, Antifungal, and Antioxidant Activities of Silver Nanoparticles Biosynthesized from Bauhinia tomentosa Linn
Abstract
:1. Introduction
2. Materials and Methods
2.1. Materials
2.2. Origin of B. tomentosa Linn flowers
2.3. Preliminary Phytochemical Analysis
2.4. Bacterial and Fungal Cultures
2.5. Synthesis of Silver Nanoparticles
2.6. Characterization of Silver Nanoparticles
2.7. Antimicrobial Activities of Biosynthesized AgNPs
2.7.1. Antibacterial Activity
2.7.2. Antifungal Activity
2.8. In Vitro Determination of Antioxidant Activity
2.9. Molecular Docking of Silver Nanoparticles
2.10. Statistical Analysis
3. Results
3.1. Phytochemical Analysis
3.2. Biosynthesis of AgNPs
3.3. Fourier-Transform Infrared Analysis of Biosynthesized AgNPs
3.4. Energy-Dispersive Spectroscopy Analysis of Biosynthesized AgNPs
3.5. X-ray Diffraction Analysis of Biosynthesized AgNPs
3.6. Scanning Electron Microscopic Analysis Biosynthesized AgNPs
3.7. Antibacterial Activity of Biosynthesized AgNPs
3.8. Antifungal Activity of Biosynthesized AgNPs
3.9. Antioxidant Activity of Biosynthesized AgNPs
3.10. Molecular Docking of Biosynthesized AgNPs
4. Discussion
5. Conclusions
Author Contributions
Funding
Institutional Review Board Statement
Informed Consent Statement
Data Availability Statement
Conflicts of Interest
References
- Prestinaci, F.; Pezzotti, P.; Pantosti, A. Antimicrobial resistance: A global multifaceted phenomenon. Pathog. Glob. Health 2015, 109, 309–318. [Google Scholar] [CrossRef] [PubMed] [Green Version]
- Morehead, M.S.; Scarbrough, C. Emergence of global antibiotic resistance. Prim. Care 2018, 45, 467–484. [Google Scholar] [CrossRef]
- Loo, Y.Y.; Rukayadi, Y.; Nor-Khaizura, M.A.; Kuan, C.H.; Chieng, B.W.; Nishibuchi, M.; Radu, S. In vitro antimicrobial activity of green synthesized silver nanoparticles against selected gram-negative foodborne pathogens. Front. Microbiol. 2018, 9, 1555. [Google Scholar] [CrossRef] [PubMed]
- Dakal, T.C.; Kumar, A.; Majumdar, R.S.; Yadav, V. Mechanistic basis of antimicrobial actions of silver nanoparticles. Front. Microbiol. 2016, 7, 1831. [Google Scholar] [CrossRef] [PubMed] [Green Version]
- Mare, A.D.; Ciurea, C.N.; Man, A.; Mareș, M.; Toma, F.; Berța, L.; Tanase, C. In vitro antifungal activity of silver nanoparticles biosynthesized with beech bark extract. Plants 2021, 10, 2153. [Google Scholar] [CrossRef]
- Galúcio, J.M.P.; de Souza, S.G.B.; Vasconcelos, A.A.; Lima, A.K.O.; da Costa, K.S.; de Campos Braga, H.; Taube, P.S. Synthesis, characterization, applications, and toxicity of green synthesized nanoparticles. Curr. Pharm. Biotechnol. 2021, 22. [Google Scholar] [CrossRef] [PubMed]
- Formoso, P.; Muzzalupo, R.; Tavano, L.; De Filpo, G.; Nicoletta, F.P. Nanotechnology for the environment and medicine. Mini Rev. Med. Chem. 2016, 16, 668–675. [Google Scholar] [CrossRef]
- Almatroudi, A. Silver nanoparticles: Synthesis, characterisation and biomedical applications. Open Life Sci. 2020, 15, 819–839. [Google Scholar] [CrossRef] [PubMed]
- Lee, S.H.; Jun, B.H. Silver nanoparticles: Synthesis and application for nanomedicine. Int. J. Mol. Sci. 2019, 20, 865. [Google Scholar] [CrossRef] [Green Version]
- Shanmuganathan, R.; Karuppusamy, I.; Saravanan, M.; Muthukumar, H.; Ponnuchamy, K.; Ramkumar, V.S.; Pugazhendhi, A. Synthesis of silver nanoparticles and their biomedical applications—A comprehensive review. Curr. Pharm. Des. 2019, 25, 2650–2660. [Google Scholar] [CrossRef] [PubMed]
- Zhang, X.F.; Liu, Z.G.; Shen, W.; Gurunathan, S. Silver nanoparticles: Synthesis, characterization, properties, applications, and therapeutic approaches. Int. J. Mol. Sci. 2016, 17, 1534. [Google Scholar] [CrossRef] [PubMed]
- Robinson, J.R.; Isikhuemhen, O.S.; Anike, F.N. Fungal-metal interactions: A review of toxicity and homeostasis. J. Fungi 2021, 7, 225. [Google Scholar] [CrossRef] [PubMed]
- Wahab, S.; Khan, T.; Adil, M.; Khan, A. Mechanistic aspects of plant-based silver nanoparticles against multi-drug resistant bacteria. Heliyon 2021, 7, e07448. [Google Scholar] [CrossRef]
- Bruna, T.; Maldonado-Bravo, F.; Jara, P.; Caro, N. Silver nanoparticles and their antibacterial applications. Int. J. Mol. Sci. 2021, 22, 7202. [Google Scholar] [CrossRef] [PubMed]
- Tortella, G.; Rubilar, O.; Fincheira, P.; Pieretti, J.C.; Duran, P.; Lourenço, I.M.; Seabra, A.B. Bactericidal and virucidal activities of biogenic metal-based nanoparticles: Advances and perspectives. Antibiotics 2021, 10, 783. [Google Scholar] [CrossRef]
- Tortella, G.R.; Pieretti, J.C.; Rubilar, O.; Fernández-Baldo, M.; Benavides-Mendoza, A.; Diez, M.C.; Seabra, A.B. Silver, copper and copper oxide nanoparticles in the fight against human viruses: Progress and perspectives. Crit. Rev. Biotechnol. 2021, 1–19. [Google Scholar] [CrossRef]
- Kelkawi, A.H.A.; Abbasi Kajani, A.; Bordbar, A.K. Green synthesis of silver nanoparticles using Mentha pulegium and investigation of their antibacterial, antifungal and anticancer activity. IET Nanobiotechnol. 2017, 11, 370–376. [Google Scholar] [CrossRef]
- Curulli, A. Nanomaterials in electrochemical sensing area: Applications and challenges in food analysis. Molecules 2020, 25, 5759. [Google Scholar] [CrossRef]
- Sainio, S.; Leppänen, E.; Mynttinen, E.; Palomäki, T.; Wester, N.; Etula, J.; Isoaho, N.; Peltola, E.; Koehne, J.; Meyyappan, M.; et al. Integrating carbon nanomaterials with metals for bio-sensing applications. Mol. Neurobiol. 2020, 57, 179–190. [Google Scholar] [CrossRef] [Green Version]
- Poulose, S.; Panda, T.; Nair, P.P.; Théodore, T. Biosynthesis of silver nanoparticles. J. Nanosci. Nanotechnol. 2014, 14, 2038–2049. [Google Scholar] [CrossRef] [PubMed]
- Sachin, K.; Karn, S.K. Microbial fabricated nanosystems: Applications in drug delivery and targeting. Front. Chem. 2021, 9, 617353. [Google Scholar] [CrossRef]
- Gomes, H.I.O.; Martins, C.S.M.; Prior, J.A.V. Silver nanoparticles as carriers of anticancer drugs for efficient target treatment of cancer cells. Nanomaterials 2021, 11, 964. [Google Scholar] [CrossRef]
- Slavin, Y.N.; Asnis, J.; Häfeli, U.O.; Bach, H. Metal nanoparticles: Understanding the mechanisms behind antibacterial activity. J. Nanobiotechnol. 2017, 15, 65. [Google Scholar] [CrossRef]
- Hu, D.; Gu, X.; Si, W.; Qin, W.; Jiao, J.; Hao, Y. Biosynthesis of silver nanoparticles using Bauhinia acuminate flower extract and their effect to promote osteogenesis of MSCs and improve meniscus injury healing. J. Photochem. Photobiol. B 2019, 197, 111536. [Google Scholar] [CrossRef]
- Morais, M.; Teixeira, A.L.; Dias, F.; Machado, V.; Medeiros, R.; Prior, J.A.V. Cytotoxic effect of silver nanoparticles synthesized by green methods in cancer. J. Med. Chem. 2020, 63, 14308–14335. [Google Scholar] [CrossRef] [PubMed]
- Ruiz-Pulido, G.; Medina, D.I.; Barani, M.; Rahdar, A.; Sargazi, G.; Baino, F.; Pandey, S. Nanomaterials for the diagnosis and treatment of head and neck cancers: A review. Materials 2021, 14, 3706. [Google Scholar] [CrossRef]
- Saha, P.; Mahiuddin, M.; Islam, A.; Ochiai, B. Biogenic synthesis and catalytic efficacy of silver nanoparticles based on peel extracts of citrus macroptera fruit. ACS Omega 2021, 6, 18260–18268. [Google Scholar] [CrossRef]
- Li, P.J.; Pan, J.J.; Tao, L.J.; Li, X.; Su, D.L.; Shan, Y.; Li, H.Y. Green synthesis of silver nanoparticles by extracellular extracts from aspergillus japonicus pj01. Molecules 2021, 26, 4479. [Google Scholar] [CrossRef]
- Santos, T.S.; Silva, T.M.; Cardoso, J.C.; Albuquerque-Júnior, R.L.C.; Zielinska, A.; Souto, E.B.; Severino, P.; Mendonça, M.D.C. Biosynthesis of silver nanoparticles mediated by entomopathogenic fungi: Antimicrobial resistance, nanopesticides, and toxicity. Antibiotics 2021, 10, 852. [Google Scholar] [CrossRef]
- Maghimaa, M.; Alharbi, S.A. Green synthesis of silver nanoparticles from Curcuma longa L. and coating on the cotton fabrics for antimicrobial applications and wound healing activity. J. Photochem. Photobiol. B 2020, 204, 111806. [Google Scholar] [CrossRef] [PubMed]
- Lagashetty, A.; Ganiger, S.K.; Shashidhar. Synthesis, characterization and antibacterial study of Ag-Au bi-metallic nanocomposite by bioreduction using piper betle leaf extract. Heliyon 2019, 5, e02794. [Google Scholar] [CrossRef] [Green Version]
- Gholami, M.; Shahzamani, K.; Marzban, A.; Lashgarian, H.E. Evaluation of antimicrobial activity of synthesised silver nanoparticles using Thymus kotschyanus aqueous extract. IET Nanobiotechnol. 2018, 12, 1114–1117. [Google Scholar] [CrossRef]
- Khalilzadeh, M.A.; Borzoo, M. Green synthesis of silver nanoparticles using onion extract and their application for the preparation of a modified electrode for determination of ascorbic acid. J. Food Drug Anal. 2016, 24, 796–803. [Google Scholar] [CrossRef]
- Keshari, A.K.; Srivastava, R.; Singh, P.; Yadav, V.B.; Nath, G. Antioxidant and antibacterial activity of silver nanoparticles synthesized by Cestrum nocturnum. J. Ayurveda Integr. Med. 2020, 11, 37–44. [Google Scholar] [CrossRef]
- Kannan, N.; Renitta, R.E.; Guruvayoorappan, C. Bauhinia tomentosa stimulates the immune system and scavenges free radical generation in vitro. J. Basic Clin. Physiol. Pharmacol. 2010, 21, 157–168. [Google Scholar] [CrossRef]
- Kannan, N.; Guruvayoorappan, C. Protective effect of Bauhinia tomentosa on acetic acid induced ulcerative colitis by regulating antioxidant and inflammatory mediators. Int. Immunopharmacol. 2013, 16, 57–66. [Google Scholar] [CrossRef]
- Kannan, N.; Sakthivel, K.M.; Guruvayoorappan, C. Anti-tumor and chemoprotective effect of bauhinia tomentosa by regulating growth factors and inflammatory mediators. Asian Pac. J. Cancer Prev. 2015, 16, 8119–8126. [Google Scholar] [CrossRef]
- Devaki, K.; Beulah, U.; Akila, G.; Narmadha, R.; Gopalakrishnan, V.K. Glucose lowering effect of aqueous extract of Bauhinia tomentosa L. on alloxan induced type 2 diabetes mellitus in wistar albino rats. J. Basic Clin. Pharm. 2011, 2, 167–174. [Google Scholar] [PubMed]
- Dugasani, S.; Balijepalli, M.K.; Tandra, S.; Pichika, M.R. Antimicrobial activity of Bauhinia tomentosa and Bauhinia vahlii roots. Pharmacogn. Mag. 2010, 6, 204–207. [Google Scholar] [CrossRef] [Green Version]
- Radha, R.; Vasantha, V.S.; Pitchumani, K. Chemical constituents from the flowering buds of Bauhinia tomentosa Linn (FBBT). Nat. Prod. Res. 2016, 30, 1670–1674. [Google Scholar] [CrossRef] [PubMed]
- Lakshminarayanan, S.; Shereen, M.F.; Niraimathi, K.L.; Brindha, P.; Arumugam, A. One-pot green synthesis of iron oxide nanoparticles from Bauhinia tomentosa: Characterization and application towards synthesis of 1, 3 diolein. Sci. Rep. 2021, 11, 8643. [Google Scholar] [CrossRef]
- Cechinel Filho, V. Chemical composition and biological potential of plants from the genus Bauhinia. Phytother. Res. 2009, 23, 1347–1354. [Google Scholar] [CrossRef]
- Singh, H.; Du, J.; Singh, P.; Yi, T.H. Ecofriendly synthesis of silver and gold nanoparticles by Euphrasia officinalis leaf extract and its biomedical applications. Artif. Cells Nanomed. Biotechnol. 2018, 46, 1163–1170. [Google Scholar] [CrossRef] [Green Version]
- Li, Z.; Ali, I.; Qiu, J.; Zhao, H.; Ma, W.; Bai, A.; Wang, D.; Li, J. Eco-friendly and facile synthesis of antioxidant, antibacterial and anticancer dihydromyricetin-mediated silver nanoparticles. Int. J. Nanomed. 2021, 16, 481–492. [Google Scholar] [CrossRef] [PubMed]
- Singh, P.; Pandit, S.; Jers, C.; Joshi, A.S.; Garnæs, J.; Mijakovic, I. Silver nanoparticles produced from Cedecea sp. exhibit antibiofilm activity and remarkable stability. Sci. Rep. 2021, 11, 12619. [Google Scholar] [CrossRef]
- Ghosh, S.; Ahmad, R.; Zeyaullah, M.; Khare, S.K. Microbial nano-factories: Synthesis and biomedical applications. Front. Chem. 2021, 9, 626834. [Google Scholar] [CrossRef]
- Ansar, S.; Tabassum, H.; Aladwan, N.S.M.; Naiman Ali, M.; Almaarik, B.; AlMahrouqi, S.; Abudawood, M.; Banu, N.; Alsubki, R. Eco friendly silver nanoparticles synthesis by Brassica oleracea and its antibacterial, anticancer and antioxidant properties. Sci. Rep. 2020, 10, 18564. [Google Scholar] [CrossRef]
- Khan, T.; Sankhe, K.; Suvarna, V.; Sherje, A.; Patel, K.; Dravyakar, B. DNA gyrase inhibitors: Progress and synthesis of potent compounds as antibacterial agents. Biomed. Pharmacother. 2018, 103, 923–938. [Google Scholar] [CrossRef]
- Lah, L.; Podobnik, B.; Novak, M.; Korošec, B.; Berne, S.; Vogelsang, M.; Kraševec, N.; Zupanec, N.; Stojan, J.; Bohlmann, J.; et al. The versatility of the fungal cytochrome P450 monooxygenase system is instrumental in xenobiotic detoxification. Mol. Microbiol. 2011, 81, 1374–1389. [Google Scholar] [CrossRef] [Green Version]
- Gupta, P.; Verma, R.; Verma, A.K.; Chattopadhyay, P.C. A versatile tool in controlling aggregation and Ag nanoparticles assisted in vitro folding of thermally denatured zDHFR. Biochem. Biophys. Rep. 2020, 24, 100856. [Google Scholar] [CrossRef]
- Hargrove, T.Y.; Friggeri, L.; Wawrzak, Z.; Qi, A.; Hoekstra, W.J.; Schotzinger, R.J.; York, J.D.; Guengerich, F.P.; Lepesheva, G.I. Structural analyses of Candida albicans sterol 14α-demethylase complexed with azole drugs address the molecular basis of azole-mediated inhibition of fungal sterol biosynthesis. J. Biol. Chem. 2017, 292, 6728–6743. [Google Scholar] [CrossRef] [Green Version]
- Mishra, M.; Huang, J.; Lee, Y.Y.; Chua, D.S.; Lin, X.; Hu, J.M.; Heese, K. Gastrodia elata modulates amyloid precursor protein cleavage and cognitive functions in mice. Biosci. Trends 2011, 5, 129–138. [Google Scholar] [CrossRef] [PubMed] [Green Version]
- Feng, L.; Manavalan, A.; Mishra, M.; Sze, S.K.; Hu, J.M.; Heese, K. Tianma modulates blood vessel tonicity. Open Biochem. J. 2012, 6, 56–65. [Google Scholar] [CrossRef]
- Renganathan, S.; Manokaran, S.; Vasanthakumar, P.; Singaravelu, U.; Kim, P.S.; Kutzner, A.; Heese, K. Phytochemical profiling in conjunction with in vitro and in silico studies to identify human α-amylase inhibitors in Leucaena leucocephala (Lam.) De Wit for the treatment of diabetes mellitus. ACS Omega 2021, 6, 19045–19057. [Google Scholar] [CrossRef]
- Harborne, A.J. Phytochemical Methods A Guide to Modern Techniques of Plant. Analysis, 3rd ed.; Chapman & Hall: London, UK, 1998. [Google Scholar]
- Ashraf, A.; Zafar, S.; Zahid, K.; Salahuddin Shah, M.; Al-Ghanim, K.A.; Al-Misned, F.; Mahboob, S. Synthesis, characterization, and antibacterial potential of silver nanoparticles synthesized from Coriandrum sativum L. J. Infect. Public Health 2019, 12, 275–281. [Google Scholar] [CrossRef]
- Kgatshe, M.; Aremu, O.S.; Katata-Seru, L.; Gopane, R. Characterization and antibacterial activity of biosynthesized silver nanoparticles using the ethanolic extract of Pelargonium sidoides DC. J. Nanomater. 2019, 2019, 3501234. [Google Scholar] [CrossRef] [Green Version]
- Bernardo-Mazariegos, E.; Valdez-Salas, B.; González-Mendoza, D.; Abdelmoteleb, A.; Tzintzun Camacho, O.; Ceceña Duran, C.; Gutiérrez-Miceli, F. Silver nanoparticles from Justicia spicigera and their antimicrobial potentialities in the biocontrol of foodborne bacteria and phytopathogenic fungi. Rev. Argent. Microbiol. 2019, 51, 103–109. [Google Scholar] [CrossRef]
- Ashraf, J.M.; Ansari, M.A.; Khan, H.M.; Alzohairy, M.A.; Choi, I. Green synthesis of silver nanoparticles and characterization of their inhibitory effects on AGEs formation using biophysical techniques. Sci. Rep. 2016, 6, 20414. [Google Scholar] [CrossRef] [PubMed] [Green Version]
- Nandiyanto, A.B.D.; Oktiani, R.; Ragadhita, R. How to read and interpret FTIR spectroscope of organic material. Indones. J. Sci. Technol. 2019, 4, 97–118. [Google Scholar] [CrossRef]
- Shehzad, A.; Qureshi, M.; Jabeen, S.; Ahmad, R.; Alabdalall, A.H.; Aljafary, M.A.; Al-Suhaimi, E. Synthesis, characterization and antibacterial activity of silver nanoparticles using Rhazya stricta. PeerJ 2018, 6, e6086. [Google Scholar] [CrossRef] [Green Version]
- Goudarzi, M.; Mir, N.; Mousavi-Kamazani, M.; Bagheri, S.; Salavati-Niasari, M. Biosynthesis and characterization of silver nanoparticles prepared from two novel natural precursors by facile thermal decomposition methods. Sci. Rep. 2016, 6, 32539. [Google Scholar] [CrossRef]
- Abbai, R.; Mathiyalagan, R.; Markus, J.; Kim, Y.J.; Wang, C.; Singh, P.; Ahn, S.; Farh Mel, A.; Yang, D.C. Green synthesis of multifunctional silver and gold nanoparticles from the oriental herbal adaptogen: Siberian ginseng. Int. J. Nanomed. 2016, 11, 3131–3143. [Google Scholar] [CrossRef] [Green Version]
- Bunaciu, A.A.; Udriştioiu, E.G.; Aboul-Enein, H.Y. X-ray diffraction: Instrumentation and applications. Crit. Rev. Anal. Chem. 2015, 45, 289–299. [Google Scholar] [CrossRef] [PubMed]
- Nayak, D.; Ashe, S.; Rauta, P.R.; Nayak, B. Biosynthesis, characterisation and antimicrobial activity of silver nanoparticles using Hibiscus rosa-sinensis petals extracts. IET Nanobiotechnol. 2015, 9, 288–293. [Google Scholar] [CrossRef] [PubMed]
- Karthik, C.S.; Manukumar, H.M.; Ananda, A.P.; Nagashree, S.; Rakesh, K.P.; Mallesha, L.; Qin, H.L.; Umesha, S.; Mallu, P.; Krishnamurthy, N.B. Synthesis of novel benzodioxane midst piperazine moiety decorated chitosan silver nanoparticle against biohazard pathogens and as potential anti-inflammatory candidate: A molecular docking studies. Int. J. Biol. Macromol. 2018, 108, 489–502. [Google Scholar] [CrossRef] [PubMed]
- Ramar, K.; Vasanthakumar, V.; Priyadharsan, A.; Priya, P.; Raj, V.; Anbarasan, P.M.; Vasanthakumari, R.; Jafar Ahamed, A. Green synthetic approach of silver nanoparticles from Bauhinia tomentosa Linn. leaves extract for potent photocatalytic and in vitro biological applications. J. Mater. Sci. Mater. Electron. 2018, 29, 11509–11520. [Google Scholar] [CrossRef]
- Pei, J.; Fu, B.; Jiang, L.; Sun, T. Biosynthesis, characterization, and anticancer effect of plant-mediated silver nanoparticles using Coptis chinensis. Int. J. Nanomed. 2019, 14, 1969–1978. [Google Scholar] [CrossRef] [PubMed] [Green Version]
- Bocate, K.P.; Reis, G.F.; de Souza, P.C.; Oliveira Junior, A.G.; Durán, N.; Nakazato, G.; Furlaneto, M.C.; de Almeida, R.S.; Panagio, L.A. Antifungal activity of silver nanoparticles and simvastatin against toxigenic species of Aspergillus. Int. J. Food Microbiol. 2019, 291, 79–86. [Google Scholar] [CrossRef] [PubMed]
- Hussain, A.; Alajmi, M.F.; Khan, M.A.; Pervez, S.A.; Ahmed, F.; Amir, S.; Husain, F.M.; Khan, M.S.; Shaik, G.M.; Hassan, I.; et al. Biosynthesized silver nanoparticle (AgNP) from Pandanus odorifer leaf extract exhibits anti-metastasis and anti-biofilm potentials. Front. Microbiol. 2019, 10, 8. [Google Scholar] [CrossRef] [Green Version]
- Schneidman-Duhovny, D.; Inbar, Y.; Nussinov, R.; Wolfson, H.J. PatchDock and SymmDock: Servers for rigid and symmetric docking. Nucleic. Acids Res. 2005, 33, W363–W367. [Google Scholar] [CrossRef] [PubMed] [Green Version]
- Pramanik, S.; Kutzner, A.; Heese, K. Lead discovery and in silico 3D structure modeling of tumorigenic FAM72A (p17). Tumour Biol. 2015, 36, 239–249. [Google Scholar] [CrossRef]
- Pramanik, S.; Kutzner, A.; Heese, K. 3D structure, dimerization modeling, and lead discovery by ligand-protein interaction analysis of p60 transcription regulator protein (p60TRP). Mol. Inform. 2016, 35, 99–108. [Google Scholar] [CrossRef] [PubMed]
- Pramanik, S.; Thaker, M.; Perumal, A.G.; Ekambaram, R.; Poondla, N.; Schmidt, M.; Kim, P.S.; Kutzner, A.; Heese, K. Proteomic atomics reveals a distinctive uracil-5-methyltransferase. Mol. Inform. 2020, 39, e1900135. [Google Scholar] [CrossRef]
- Patil, M.P.; Singh, R.D.; Koli, P.B.; Patil, K.T.; Jagdale, B.S.; Tipare, A.R.; Kim, G.D. Antibacterial potential of silver nanoparticles synthesized using Madhuca longifolia flower extract as a green resource. Microb. Pathog. 2018, 121, 184–189. [Google Scholar] [CrossRef]
- Wang, C.; Mathiyalagan, R.; Kim, Y.J.; Castro-Aceituno, V.; Singh, P.; Ahn, S.; Wang, D.; Yang, D.C. Rapid green synthesis of silver and gold nanoparticles using Dendropanax morbifera leaf extract and their anticancer activities. Int. J. Nanomed. 2016, 11, 3691–3701. [Google Scholar] [CrossRef] [Green Version]
- Geethalakshmi, R.; Sarada, D.V. Gold and silver nanoparticles from Trianthema decandra: Synthesis, characterization, and antimicrobial properties. Int. J. Nanomed. 2012, 7, 5375–5384. [Google Scholar] [CrossRef] [Green Version]
- Liao, C.; Li, Y.; Tjong, S.C. Bactericidal and Cytotoxic Properties of Silver Nanoparticles. Int. J. Mol. Sci. 2019, 20, 449. [Google Scholar] [CrossRef] [PubMed] [Green Version]
- Khalandi, B.; Asadi, N.; Milani, M.; Davaran, S.; Abadi, A.J.; Abasi, E.; Akbarzadeh, A. A review on potential role of silver nanoparticles and possible mechanisms of their actions on bacteria. Drug Res. (Stuttg.) 2017, 67, 70–76. [Google Scholar] [CrossRef] [PubMed]
- Balakumaran, M.D.; Ramachandran, R.; Balashanmugam, P.; Mukeshkumar, D.J.; Kalaichelvan, P.T. Mycosynthesis of silver and gold nanoparticles: Optimization, characterization and antimicrobial activity against human pathogens. Microbiol. Res. 2016, 182, 8–20. [Google Scholar] [CrossRef]
- Durán, N.; Nakazato, G.; Seabra, A.B. Antimicrobial activity of biogenic silver nanoparticles, and silver chloride nanoparticles: An overview and comments. Appl. Microbiol. Biotechnol. 2016, 100, 6555–6570. [Google Scholar] [CrossRef] [PubMed]
- Ronkin, S.M.; Badia, M.; Bellon, S.; Grillot, A.L.; Gross, C.H.; Grossman, T.H.; Mani, N.; Parsons, J.D.; Stamos, D.; Trudeau, M.; et al. Discovery of pyrazolthiazoles as novel and potent inhibitors of bacterial gyrase. Bioorg. Med. Chem. Lett. 2010, 20, 2828–2831. [Google Scholar] [CrossRef]
- Hearnshaw, S.J.; Chung, T.T.; Stevenson, C.E.; Maxwell, A.; Lawson, D.M. The role of monovalent cations in the ATPase reaction of DNA gyrase. Acta Crystallogr. D Biol. Crystallogr. 2015, 71, 996–1005. [Google Scholar] [CrossRef] [PubMed] [Green Version]
- Zhang, J.; Li, L.; Lv, Q.; Yan, L.; Wang, Y.; Jiang, Y. The Fungal CYP51s: Their Functions, Structures, Related Drug Resistance, and Inhibitors. Front. Microbiol. 2019, 10, 691. [Google Scholar] [CrossRef] [PubMed]
- DeJarnette, C.; Luna-Tapia, A.; Estredge, L.R.; Palmer, G.E. Dihydrofolate reductase is a valid target for antifungal development in the human pathogen candida albicans. mSphere 2020, 5, e00374-20. [Google Scholar] [CrossRef]
- Kedi, P.B.E.; Meva, F.E.; Kotsedi, L.; Nguemfo, E.L.; Zangueu, C.B.; Ntoumba, A.A.; Mohamed, H.E.A.; Dongmo, A.B.; Maaza, M. Eco-friendly synthesis, characterization, in vitro and in vivo anti-inflammatory activity of silver nanoparticle-mediated Selaginella myosurus aqueous extract. Int. J. Nanomed. 2018, 13, 8537–8548. [Google Scholar] [CrossRef] [Green Version]
- Akter, M.; Sikder, M.T.; Rahman, M.M.; Ullah, A.; Hossain, K.F.B.; Banik, S.; Hosokawa, T.; Saito, T.; Kurasaki, M. A systematic review on silver nanoparticles-induced cytotoxicity: Physicochemical properties and perspectives. J. Adv. Res. 2018, 9, 1–16. [Google Scholar] [CrossRef] [PubMed]
- Al-Huqail, A.A.; Hatata, M.M.; Al-Huqail, A.A.; Ibrahim, M.M. Preparation, characterization of silver phyto nanoparticles and their impact on growth potential of Lupinus termis L. seedlings. Saudi J. Biol. Sci 2018, 25, 313–319. [Google Scholar] [CrossRef] [PubMed]
- Chiguvare, H.; Oyedeji, O.O.; Matewu, R.; Aremu, O.; Oyemitan, I.A.; Oyedeji, A.O.; Nkeh-Chungag, B.N.; Songca, S.P.; Mohan, S.; Oluwafemi, O.S. Synthesis of silver nanoparticles using buchu plant extracts and their analgesic properties. Molecules 2016, 21, 774. [Google Scholar] [CrossRef] [PubMed] [Green Version]
- Jadou, A.; Al-Shahwany, A.W. Biogenic Synthesis and Characterization of Silver Nanoparticles Using Some Medical Plants and Evaluation of Their Antibacterial and Toxicity Potential. J. AOAC Int. 2018, 101, 1905–1912. [Google Scholar] [CrossRef]
- Erdogan, O.; Abbak, M.; Demirbolat, G.M.; Birtekocak, F.; Aksel, M.; Pasa, S.; Cevik, O. Green synthesis of silver nanoparticles via Cynara scolymus leaf extracts: The characterization, anticancer potential with photodynamic therapy in MCF7 cells. PLoS ONE 2019, 14, e0216496. [Google Scholar] [CrossRef] [PubMed] [Green Version]
- Shahriari Ahmadi, F.; Tanhaeian, A.; Habibi Pirkohi, M. Biosynthesis of silver nanoparticles using chlamydomonas reinhardtii and its inhibitory effect on growth and virulence of listeria monocytogenes. Iran. J. Biotechnol. 2016, 14, 163–168. [Google Scholar] [CrossRef] [Green Version]
- Lukman, A.I.; Gong, B.; Marjo, C.E.; Roessner, U.; Harris, A.T. Facile synthesis, stabilization, and anti-bacterial performance of discrete Ag nanoparticles using Medicago sativa seed exudates. J. Colloid. Interface Sci. 2011, 353, 433–444. [Google Scholar] [CrossRef] [PubMed]
- Xia, Q.H.; Zheng, L.P.; Zhao, P.F.; Wang, J.W. Biosynthesis of silver nanoparticles using Artemisia annua callus for inhibiting stem-end bacteria in cut carnation flowers. IET Nanobiotechnol. 2017, 11, 185–192. [Google Scholar] [CrossRef]
- Kharat, S.N.; Mendhulkar, V.D. Synthesis, characterization and studies on antioxidant activity of silver nanoparticles using Elephantopus scaber leaf extract. Mater. Sci. Eng. C Mater. Biol. Appl. 2016, 62, 719–724. [Google Scholar] [CrossRef] [PubMed]
- Nagaich, U.; Gulati, N.; Chauhan, S. Antioxidant and antibacterial potential of silver nanoparticles: Biogenic synthesis utilizing apple extract. J. Pharm. (Cairo) 2016, 2016, 7141523. [Google Scholar] [CrossRef]
- Yugandhar, P.; Haribabu, R.; Savithramma, N. Synthesis, characterization and antimicrobial properties of green-synthesised silver nanoparticles from stem bark extract of Syzygium alternifolium (Wt.) Walp. 3 Biotech 2015, 5, 1031–1039. [Google Scholar] [CrossRef] [Green Version]
- Sanjenbam, P.; Gopal, J.V.; Kannabiran, K. Anticandidal activity of silver nanoparticles synthesized using Streptomyces sp.VITPK1. J. Mycol. Med. 2014, 24, 211–219. [Google Scholar] [CrossRef] [PubMed]
- Vyshnava, S.S.; Kanderi, D.K.; Panjala, S.P.; Pandian, K.; Bontha, R.R.; Goukanapalle, P.K.; Banaganapalli, B. Effect of silver nanoparticles against the formation of biofilm by pseudomonas aeruginosa an in silico approach. Appl. Biochem. Biotechnol. 2016, 180, 426–437. [Google Scholar] [CrossRef] [PubMed]

| S. No. | Test | Aqueous Extract | Alcohol Extract |
|---|---|---|---|
| 1 | Alkaloids | + | + |
| 2 | Antroquinone | ++ | + |
| 3 | Coumarins | ++ | + |
| 4 | Flavonoids | ++ | + |
| 5 | Glycoside | + | + |
| 6 | Polyphenol | ++ | + |
| 7 | Saponin | ++ | + |
| 8 | Steroids | ++ | + |
| 9 | Tannin | + | − |
| 10 | Terpenoids | + | + |
| 11 | Triterpenoids | + | + |
| Elements | Atomic Number (Periodic Table of Elements) | Shells | Weight % | Atomic % |
|---|---|---|---|---|
| Ag | 47 | L-series | 75.86 | 59.08 |
| Cl | 17 | K-series | 25.14 | 41.92 |
| Total | 100 | 100 |
| Antioxidant Efficacy, AgNPs $; IC50 (AgNPs & Ascorbic Acid (Control), Respectively) [μg/mL] | Antioxidant Efficacy, Other AgNPs; IC50 (AgNPs & Ascorbic Acid (Control), Respectively) [μg/mL] | Antimicrobial (Antibacterial) Efficacy, AgNPs $; Zone Inhibition [mm] | Antimicrobial (Antibacterial) Efficacy, Other AgNPs; Zone Inhibition [mm] | Antimicrobial (Antifungal) Efficacy, AgNPs $; Zone Inhibition [mm] | Antimicrobial (Antifungal) Efficacy, Other AgNPs; Zone Inhibition [mm] | References | |
|---|---|---|---|---|---|---|---|
| 1 | 56.77 & 43.03 | 50.37 & 44.10 | [47,63] | ||||
| 2 | 46.25 & 41.86 | [95] | |||||
| 3 | 6.75 (E. coli) (30 μL) | 11.4 (E. coli) (50 μL) | [57,67] | ||||
| 4 | 9.25 (S. aureus) (30 μL) | 12.7 (S. aureus) (50 μL) | [56,67] | ||||
| 5 | 5.75 (C. albicans) (30 μL) | 10.7 (C. albicans) (50 μL) | [39,97,98] | ||||
| 6 | 7 (A. Flavus) (30 μL) | 20 (A. Flavus) (50 μL) | [97,98] |
Publisher’s Note: MDPI stays neutral with regard to jurisdictional claims in published maps and institutional affiliations. |
© 2021 by the authors. Licensee MDPI, Basel, Switzerland. This article is an open access article distributed under the terms and conditions of the Creative Commons Attribution (CC BY) license (https://creativecommons.org/licenses/by/4.0/).
Share and Cite
Renganathan, S.; Subramaniyan, S.; Karunanithi, N.; Vasanthakumar, P.; Kutzner, A.; Kim, P.-S.; Heese, K. Antibacterial, Antifungal, and Antioxidant Activities of Silver Nanoparticles Biosynthesized from Bauhinia tomentosa Linn. Antioxidants 2021, 10, 1959. https://doi.org/10.3390/antiox10121959
Renganathan S, Subramaniyan S, Karunanithi N, Vasanthakumar P, Kutzner A, Kim P-S, Heese K. Antibacterial, Antifungal, and Antioxidant Activities of Silver Nanoparticles Biosynthesized from Bauhinia tomentosa Linn. Antioxidants. 2021; 10(12):1959. https://doi.org/10.3390/antiox10121959
Chicago/Turabian StyleRenganathan, Senthil, Sugunakala Subramaniyan, Nivetha Karunanithi, Preethi Vasanthakumar, Arne Kutzner, Pok-Son Kim, and Klaus Heese. 2021. "Antibacterial, Antifungal, and Antioxidant Activities of Silver Nanoparticles Biosynthesized from Bauhinia tomentosa Linn" Antioxidants 10, no. 12: 1959. https://doi.org/10.3390/antiox10121959
APA StyleRenganathan, S., Subramaniyan, S., Karunanithi, N., Vasanthakumar, P., Kutzner, A., Kim, P.-S., & Heese, K. (2021). Antibacterial, Antifungal, and Antioxidant Activities of Silver Nanoparticles Biosynthesized from Bauhinia tomentosa Linn. Antioxidants, 10(12), 1959. https://doi.org/10.3390/antiox10121959

